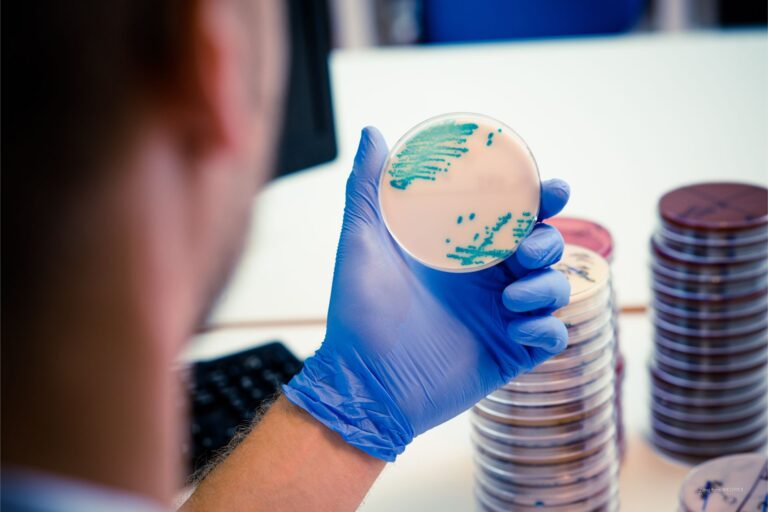

StaphySearch
Hlavný cieľ projektu
Cieľom projektu je vybudovanie komplexnej databázy, ktorá integruje údaje o stafylokokových kmeňoch z nemocničného prostredia v rámci Slovenska. Využitím multi-omics prístupu – od epidemiologických dát až po genetické analýzy – umožní databáza lepšie pochopenie šírenia a rezistencie týchto baktérií. Databáza bude slúžiť ako praktický nástroj pre výskum, klinickú prax a epidemiologické konzíliá, pričom prispeje k zníženiu nákladov v zdravotníckych zariadeniach a zároveň poskytne cenný podklad pre tvorbu nových výskumných hypotéz v oblasti mikrobiológie a verejného zdravia.
Predmet projektu
Projekt sa zameriava na zber, analýzu a spracovanie údajov o stafylokokových baktériách, pričom cieľom je preskúmať výskyt týchto baktérií, ich rezistenčné profily a rozdiely medzi jednotlivými kmeňmi. Výsledky budú uložené v jednoduchej a prístupnej databáze, ktorá lekárom a výskumníkom uľahčí rozhodovanie a zlepší prístup k prevencii a zvládaniu týchto infekcií v budúcnosti.
Jedinečnosť projektu
Projekt prináša na Slovensko nový prístup k riešeniu nemocničných infekcií spôsobených stafylokokmi. Kombinácia údajov z bežných laboratórnych vyšetrení a celogenómového sekvenovania vytvára ucelený obraz o horizontálnom génovom transfere a dynamike šírenia v nemocničnom prostredí. Projekt pomôže zlepšiť manažment v nemocničnom prostredí, a chrániť verejné zdravie pred šírením multirezistentných baktérií na základe reálnych dát.
Staphylococcus Strain Variation in Slovak hospitals
Výskumná aktivita projektu StaphySearch
Komplexná analýza stafylokokových kmeňov zo slovenských nemocníc pomocou multi-omics prístupu, vrátane celogénomového sekvenovania genómu, s cieľom sledovania výskytu, šírenie ako i antibiotickú rezistenciu daných patogénov.